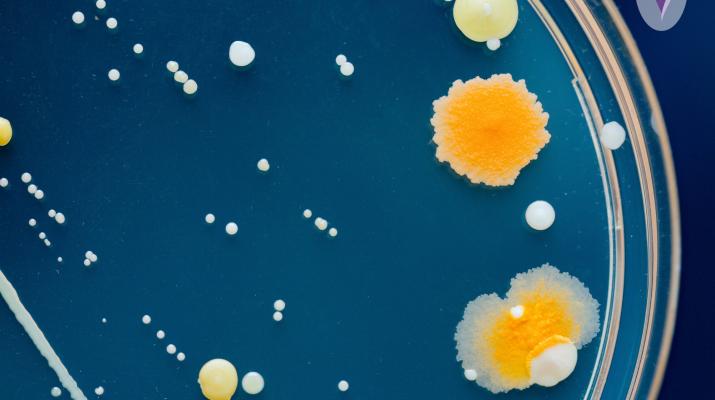

Esteu aquí
Acte de lliurament de Beques 2025-26 Rotary Club

El Rotary Club El Prat us convida a l'Acte de lliurament de Beques 2025-26, un reconeixement a l'excel·lència acadèmica i als valors humans dels estudiants del nostre municipi.
Activitats relacionades

Tardes Joves a la Palmira
Tipus: Proposta
Quan: 07/10/2025
On: Centre Cívic Palmira Domènech
Canal receptes
Tipus: Proposta
Quan: Del 08/10/2025 al 17/12/2025
On: Centre Cívic Palmira Domènech
Tarda en família: Fem ciència amb Ada Lovelace
Tipus: Proposta
Quan: 09/10/2025
On: Centre Cívic Palmira Domènech